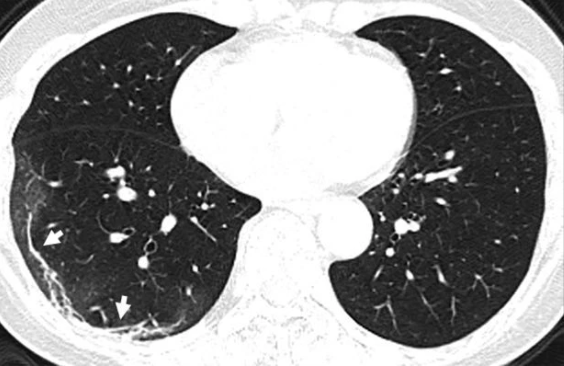

Một bệnh nhân nam làm việc tại chợ hải sản ở thành phố Vũ Hán, tỉnh Hồ Bắc (Trung Quốc) đã tử vong ở tuổi 44 vì nhiễm COVID-19. Ngày 25/12/2019, người này nhập viện với triệu chứng sốt và ho trong gần hai tuần liền. Tại đây, bác sĩ chẩn đoán ông bị viêm phổi và hội chứng suy hô hấp cấp tính. Dù đã được nỗ lực điều trị, song người đàn ông xấu số vẫn trút hơi thở cuối cùng sau một tuần chạy chữa.

Tổn thương kính mờ trên phổi được biểu hiện bằng màu đỏ.
Trong hình ảnh chụp X-quang của bệnh nhân được Hiệp hội X-quang Bắc Mỹ công bố, có thể thấy các đốm trắng xuất hiện ở góc dưới lá phổi, thường được biết đến như tổn thương kính mờ (GGO). Khi so sánh ảnh theo thứ tự từ A đến F, hiện tượng khoảng không khí trong phổi bị dịch thay thế càng rõ ràng hơn.

Ảnh X-quang của bệnh nhân nam 44 tuổi được sắp xếp theo thứ tự thời gian.
Bác sĩ cho biết đặc điểm tổn thương phổi ở các bệnh nhân COVID-19 tương tự như những bệnh nhân mắc hội chứng hô hấp cấp tính nặng (SARS) và hội chứng hô hấp Trung Đông (MERS). Cả ba dịch bệnh này đều do các chủng virus họ corona gây nên. Từ tháng 11/2002 đến tháng 7/2003, dịch SARS đã lây lan cho hơn 8.000 người dân Trung Quốc, khiến 774 người tử vong.

Ảnh chụp phổi của bệnh nhân nữ 54 tuổi.
Ảnh chụp cắt lớp lá phổi của một nữ bệnh nhân 54 tuổi bị nhiễm COVID-19 sau khi đến Vũ Hán cũng cho thấy hiện tượng tổn thương lan rộng như trên. Người phụ nữ này được chẩn đoán viêm phổi nặng do virus corona sau khi có dấu hiệu sốt, ho, mệt mỏi và tức nghẹn ở ngực trong khoảng một tuần. Bác sĩ đã cho bà thở oxy và dùng kháng sinh để đẩy lùi triệu chứng.

Tổn thương ở phổi của một người phụ nữ 45 tuổi ở tỉnh Tứ Xuyên, Trung Quốc dương tính với COVID-19.